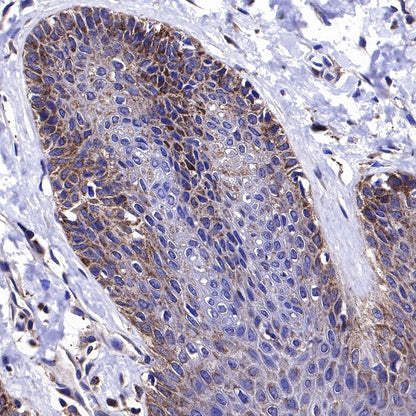

WB result of BAX Rabbit mAb
Primary antibody: BAX Rabbit mAb at 1/1000 dilution
Lane 1: Jurkat whole cell lysate 20 µg
Lane 2: HeLa whole cell lysate 20 µg
Lane 3: MCF7 whole cell lysate 20 µg
Lane 4: HepG2 whole cell lysate 20 µg
Low expression control: Jurkat whole cell lysate
Secondary antibody: Goat Anti-Rabbit IgG, (H+L), HRP conjugated at 1/10000 dilution
Predicted MW: 21kDa
Observed MW: 21kDa
Product Details
Product Details
Product Specification
| Host | Rabbit |
| Antigen | BAX |
| Synonyms | Bcl2-L-4 |
| Immunogen | Synthetic Peptide |
| Location | Cytoplasm, Mitochondrion outer membrane |
| Accession | Q07812 |
| Clone Number | SDT-338-76 |
| Antibody Type | Recombinant mAb |
| Application | WB, IHC-P |
| Reactivity | Hu, Ms, Rt |
| Predicted Reactivity | Bv |
| Purification | Protein A |
| Concentration | 0.5 mg/ml |
| Conjugation | Unconjugated |
| Physical Appearance | Liquid |
| Storage Buffer | PBS, 40% Glycerol, 0.05% BSA, 0.03% Proclin 300 |
| Stability & Storage | 12 months from date of receipt / reconstitution, -20 °C as supplied |
Dilution
| application | dilution | species |
| WB | 1:1000 | |
| IHC-P | 1:2000 |
Background
Bax and its homolog Bak are key regulators of the mitochondrial pathway of apoptosis. On cell stress Bax and Bak accumulate at distinct foci on the mitochondrial surface where they undergo a conformational change, oligomerize, and mediate cytochrome c release, leading to cell death [PMID: 27932064].
Picture
Picture
Western Blot


WB result of BAX Rabbit mAb
Primary antibody: BAX Rabbit mAb at 1/1000 dilution
Lane 1: C2C12 whole cell lysate 20 µg
Secondary antibody: Goat Anti-Rabbit IgG, (H+L), HRP conjugated at 1/10000 dilution
Predicted MW: 21kDa
Observed MW: 21kDa

WB result of BAX Rabbit mAb
Primary antibody: BAX Rabbit mAb at 1/1000 dilution
Lane 1: C6 whole cell lysate 20 µg
Secondary antibody: Goat Anti-Rabbit IgG, (H+L), HRP conjugated at 1/10000 dilution
Predicted MW: 21kDa
Observed MW: 21kDa
Immunohistochemistry

IHC shows positive staining in paraffin-embedded human skin. Anti-BAX antibody was used at 1/2000 dilution, followed by a HRP Polymer for Mouse & Rabbit IgG (ready to use). Counterstained with hematoxylin. Heat mediated antigen retrieval with Tris/EDTA buffer pH9.0 was performed before commencing with IHC staining protocol.

IHC shows positive staining in paraffin-embedded human esophagus. Anti-BAX antibody was used at 1/2000 dilution, followed by a HRP Polymer for Mouse & Rabbit IgG (ready to use). Counterstained with hematoxylin. Heat mediated antigen retrieval with Tris/EDTA buffer pH9.0 was performed before commencing with IHC staining protocol.

IHC shows positive staining in paraffin-embedded human kidney. Anti-BAX antibody was used at 1/2000 dilution, followed by a HRP Polymer for Mouse & Rabbit IgG (ready to use). Counterstained with hematoxylin. Heat mediated antigen retrieval with Tris/EDTA buffer pH9.0 was performed before commencing with IHC staining protocol.

IHC shows positive staining in paraffin-embedded human cervical squamous cell carcinoma. Anti-BAX antibody was used at 1/2000 dilution, followed by a HRP Polymer for Mouse & Rabbit IgG (ready to use). Counterstained with hematoxylin. Heat mediated antigen retrieval with Tris/EDTA buffer pH9.0 was performed before commencing with IHC staining protocol.

IHC shows positive staining in paraffin-embedded mouse kidney. Anti-BAX antibody was used at 1/2000 dilution, followed by a HRP Polymer for Mouse & Rabbit IgG (ready to use). Counterstained with hematoxylin. Heat mediated antigen retrieval with Tris/EDTA buffer pH9.0 was performed before commencing with IHC staining protocol.

IHC shows positive staining in paraffin-embedded rat kidney. Anti-BAX antibody was used at 1/2000 dilution, followed by a HRP Polymer for Mouse & Rabbit IgG (ready to use). Counterstained with hematoxylin. Heat mediated antigen retrieval with Tris/EDTA buffer pH9.0 was performed before commencing with IHC staining protocol.